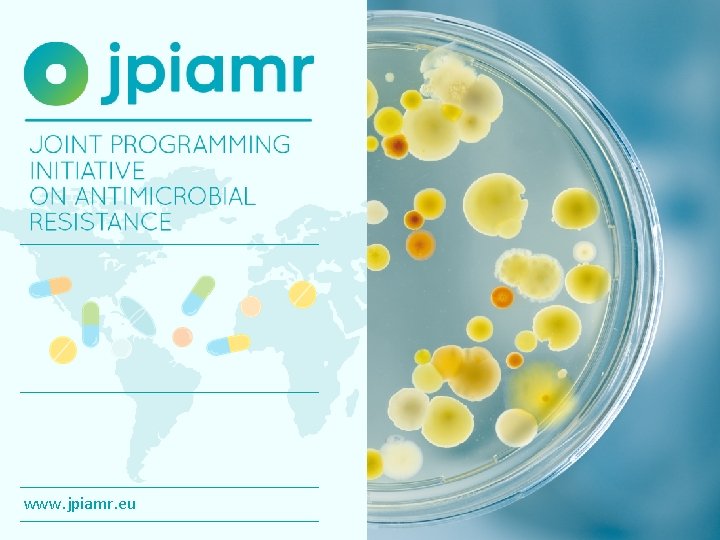
www. jpiamr. eu

www jpiamr eu JPIAMR Goals www jpiamr eu

- Slides: 17
www. jpiamr. eu
JPIAMR Goals: • www. jpiamr. eu
1. Mapping the AMR landscape funding and resources 2. Developing International Collaboration 3. Exploratory / Scoping workshops 4. Calls for Research Proposals 5. Alignment of Research Programs and AMR international policies 6. Virtual Research Institute (research infrastrucutes, research institutes and capacity building) www. jpiamr. eu
Activity: Mapping the AMR landscape funding & resources JPIAMR 2018 mapping exercises: AMR research funding: Data on project funding will be collected from JPIAMR joint calls, national funding agencies and international foundations to monitor investments in projects ranging from basic, applied and clinical research, including trials, epidemiological, public health, veterinary and environmental research related to AMR issues. AMR research projects : Project data relevant to antimicrobial resistance research undertaken in the 26 member countries, within the broad remit of the six priority topics identified in the JPIAMR Strategic Research Agenda will be included in the mapping exercise. AMR research centers/units: Collect data about such research centres that has significant contributions to AMR research. A dynamic network of such AMR research units will provide a close contact between the JPIAMR and the scientific community and would help to build research capacity in the area of AMR research infrastructure: Mapping of the existing AMR research infrastructure within the member states will better coordinate the databases and biobanks and would ensure effective interchange of valid information and samples. AMR industry alliances and development: Mapping of industries working in the AMR field and their specific needs will be conducted to improve data sharing and communication between academia and industry. www. jpiamr. eu
Activity: www. jpiamr. eu
Activity: Strategic Workshops Early Discovery of New Antibiotics, 12/13 January 2017, Paris France JPIAMR host member: France (ANR), UK (MRC) • bringing together the PIs in projects areas of antibiotic early discovery and those in clinical development to exchange experiences Environmental Dimensions of AMR, 27/28 September 2017, Göteborg Sweden JPIAMR host member: Sweden (SRC) • potential steps in a roadmap for the Environment pillar within JPIAMR. Setting the scene for a JPIAMR Virtual Research Institute, 8/9 Nov 2017, Berlin JPIAMR host member: Canada (CIHR), Germany (DLR) • Start discussions on the formation of the JPIAMR-VRI. JPIAMR funded Research Networks Workshop, 8/9 March 2018, Frankfurt • Presentaiton of the outcomes of the JPIAMR funded reserach networks and input to the VRI networks development Globalisation efforts workshops: Argentina, Poland SRi. A consultation workshops/meetings www. jpiamr. eu
Activity: SRi. A Updating the JPIAMR Strategic Research and Innovation Agenda • Text Review: Updating the text with latest scientific developments, innovation elements and needs from MIC Development of Research Priority Roadmaps • Identification of roadmaps of research priorities by SRi. A pillars to be addressed by JPIAMR www. jpiamr. eu
Activity: RESEARCH PROJECTS NETWORKS/WORKING GROUPS Interventions 9% Environment 9% Interventions 9% Therapeutics 29% Environment 9% Therapeutics 27% Transmission 14% Surveillance 4% Diagnostics 14% Transmission 49% Call Call 1. Therapeutics 2. Therapeutics 3. Transmission 4. Networks/Working Groups 5. Interventions Surveillance 27% Call 6. Therapeutics Call 7. Networks/Surveillance Call 8. Networks/VRI www. jpiamr. eu
JPIAMR Communications 2017 Structure: Communication plans, Timeline, Design, Agency, etc. Actions: EAAD, results of the 5 th Call, 6 th Call Preannouncement, newsletters, pressreleases, etc. Video: Interviews – SRA Evironment. New Members Increase JPIAMR international visibility Social Media. Twitter: Increased activity, over 1 k followers @jpionamr www. jpiamr. eu
Communications Network 2018 Share, Use and Reuse Com. Material. Listen and Collaborate. Member Communications ”Networked effect of Calls Communications”. Share knowledge and raise awareness – together. Nominate - member of network. Participate actively. Member Communications JPIAMR Secretriat Coms. Officer Member Communications Launch Q 2, 2018. www. jpiamr. eu
Total budget 2017 -2020 EXEDRA CSA 2 (Max. Grant Amount) Participant no. /Participant short name 1/SRC (Sweden) WP 1 WP 2 70. 0 WP 3 WP 4 13. 0 WP 5 8. 0 2/ANR (France) WP 6 5. 0 12, 900. 00 5. 0 6/DLR (Germany) 17. 0 7/ISCIII (Spain) 3. 0 5. 0 8/INCDMIC (Romania) 4. 0 9/MRC (UK) 2. 0 10/MINCy. T (Argentina) 8. 0 11/MINECO (Spain) 3. 0 Total Personnel costs Total Travel costs 150, 062. 00 1. 0 40, 500. 00 17, 200. 00 22, 000. 00 24, 000. 00 2. 0 22, 500. 00 15. 0 142, 500. 00 15. 0 30, 100. 00 74. 0 16. 0 37. 0 23. 0 40. 0 1, 365, 762. 00 475, 000 88, 000 242, 966 144, 500 175, 296 250, 000 1, 375, 762. 00 20, 000 5, 000 90, 000 115, 000. 00 Subcontracting Other direct costs 22, 500. 00 2. 0 4. 0 15/NCN (Poland) 831, 500. 00 50, 000. 00 3. 0 5/CSO-MOH (Israel) Total PM 35. 0 10. 0 3/ANCSI (Romania) 13/Zon. MW (Holland) Total Personnel costs 72, 000. 00 63, 000 5, 000 45, 000 50, 000 3, 000 171, 000. 00 Total budget 628, 000 93, 000 307, 966 154, 500 225, 296 325, 000 1, 733, 762. 00 Indirect costs 25% 157, 000 23, 250 76, 992 38, 625 56, 324 63, 250 415, 440. 50 Total budget 785, 000 116, 250 384, 958 193, 125 281, 620 388, 250 2, 149, 202. 50 www. jpiamr. eu
Finances reporting costs 2017 (pre-liminary) Row Labels Sweden (SRC) WP 6. Communication, dissemination and advocacy WP 1. Management & Coordination WP 4. Alignment with policy and industry Summa av Totalt 290, 522. 90 62, 545. 81 188, 642. 01 31, 900. 31 WP 2. Strategy, governance and long term sustainability 901. 58 WP 3. Globalisation and capacity extension 308. 59 WP 5. Research alignment (blank) Germany (DLR) WP 1. Management & Coordination WP 3. Globalisation and capacity extension WP 5. Research alignment Holland (Zon. Mw) 6, 224. 60 0. 00 63, 469. 24 2, 215. 63 8, 517. 00 52, 736. 61 118, 508. 75 WP 1. Management & Coordination 53, 648. 05 WP 5. Research alignment 64, 860. 70 France (ANR) WP 4. Alignment with policy and industry WP 5. Research alignment Grand Total 8, 304. 70 7, 322. 89 981. 81 480, 805. 59 www. jpiamr. eu
Highlights members in-kind contributions 2017 • www. jpiamr. eu
Activities at European Level 9 FP – activities related to GPC and JPIs Chairs group • @jpionamr www. jpiamr. eu
Activities at International Level • @jpionamr www. jpiamr. eu
EU Bilat US 4. 0 event “European Joint Programming Initiatives – Opportunities for U. S. - EU Research Collaboration on Societal Challenges” Jan 29 -31, 2018 in Washington DC Meeting objectives • Creating/raising awareness about the JPI AMR, HDHL, Water, Oceans, FACCE, Climate within the US Agencies • Identifying suitable/corresponding thematic research fields within US Programmes for potential synergies/collaborations/data exchange • Explore eventual cooperation opportunities as well as modalities between the JPIs and US Agencies on areas of common interest JPIAMR had bilateral meetings with USDA-NIFA, CDC, and NIAID. Outcome • NIFA would be interested in inviting JPIAMR PIs in Animal Health/Agriculture to joint meeting in association with ASM meeting in Atlanta June 7 -11 if JPIAMR countries and/or grants would fund participation of PIs. • NIFA will introduce language in their call 2018 encouraging US groups to apply for projects which collaborate with JPIAMR funded projects. • CDC and NIAID are also interested in pursuing plans for joint PI meetings. www. jpiamr. eu
THANK YOU! www. jpiamr. eu